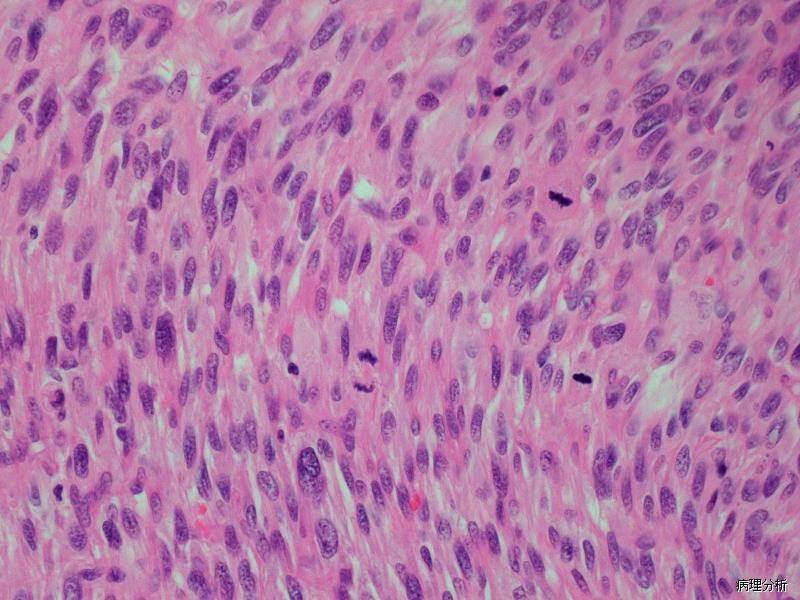

子宫梭形细胞平滑肌肉瘤
Spindle Cell Leiomyosarcoma of the Uterine
同义词(或曾用名): 平滑肌肉瘤
概述:
恶性平滑肌肿瘤,表现为梭形细胞形态。
发病部位: 子宫
诊断要点:
梭形平滑肌样细胞密集增生,呈束状、编织状或杂乱排列;
细胞中-重度核异型,细胞核呈梭形,通常末端钝圆,核深染,染色质粗,核仁明显,50%的病例可见多核细胞和破骨样细胞;少数病例细胞仅轻度异型;
核分裂指数常很高(>10 个/10 个 HPF);
1/3 病例可见坏死,坏死的特征是由增生良好的“活细胞”突然转变成坏死细胞,“活细胞”常围绕血管周围;
10-20%病例可见血管侵犯;
10-20%病例可见浸润周围组织;
细胞异型及核分裂是诊断平滑肌肉瘤的重要标准,由于无法明确区分肿瘤性坏死与梗死,使得坏死在平滑肌肉瘤中的诊断价值不确定。

免疫组织化学染色:
SMA、myosin, desmin、ER, PR, EMA、p53 常阳性; h-caldesmon、CD117 表达不一,可灶状表达 CD10。
← 子宫血管周上皮样细胞肿瘤 未分化子宫肉瘤 →
